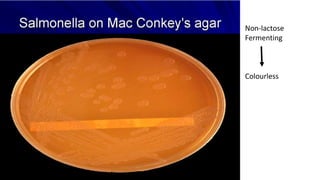
Non-lactose
Fermenting
Colourless

Typhoid fever is caused by the bacterium Salmonella typhi. It presents with a sustained fever over 3-4 weeks along with relative bradycardia and involvement of the intestinal lymphoid tissues and reticuloendothelial system. Diagnosis can be confirmed through blood cultures in the first week, serological tests like the Widal test in the second week, and stool or urine cultures later. Treatment involves antibiotics like fluoroquinolones or third generation cephalosporins. Prevention relies on sanitation measures and immunization with vaccines like the injectable Vi polysaccharide vaccine or live oral Typhoral vaccine.